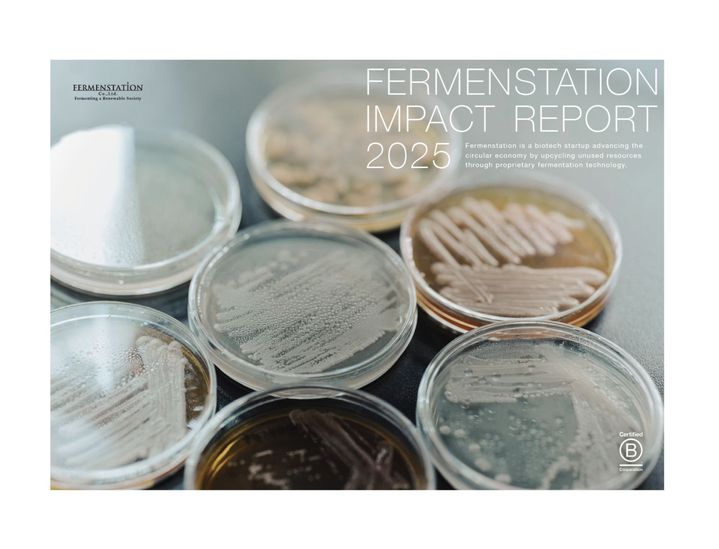

FASHION
ニュースジーユー、衣料回収「RE.GU」キャンペーンを開催 デニム廃材バッグを抽選20名にプレゼント

FASHION
ニュースリペアプログラム「Goldwin Repair Club」が始動 他社ブランドも対象

SOCIETY
ニュース遊休地が生物多様性の拠点へ 明治HD、「まほろばテラス」がSEGESのExcellent Stage 2に認定

SOCIETY
海外ニュースリサイクル率EU最低国が激変 ルーマニアで国民に定着したデポジット制度

ACTION
ニュース築野食品工業、「ViOマルシェ」に出展 米ぬか100%活用の新商品2点を代官山で初披露

LIFESTYLE
海外ニュース4月22日アースデイに考えよう 変わりゆく「ラグジュアリーの価値」
SOCIETY
ニュース未利用資源から価値を生み出す挑戦 ファーメンステーション、2025年度インパクトレポートを公開

ACTION
ニュースLUSH、フレッシュさとハンドメイドを体験できるイベント「LUSHと秘密のキッチン SEASON 3」

SOCIETY
海外ニュース揚げ物やピザを禁止 英イングランドが目指す学校給食の改革

ACTION
ニュースサンシャイン水族館「サンゴプロジェクト」が20周年 沖縄・恩納村と連携した保全活動の軌跡

SOCIETY
ニュースYKK、再生材ファスナー「NATULON®」のグローバル販売比率が50%を突破 GHGを約19.6%削減

SOCIETY
ニュース1万人のサステナプレイヤーを育む「サストレジャパンプロジェクト」が本格始動 全国サッカークラブに参画を募集

ACTION
ニュースSORGAMのローンチパーティーが銀座で開催 捨てるところのない循環型穀物で“ジャンク”を再定義